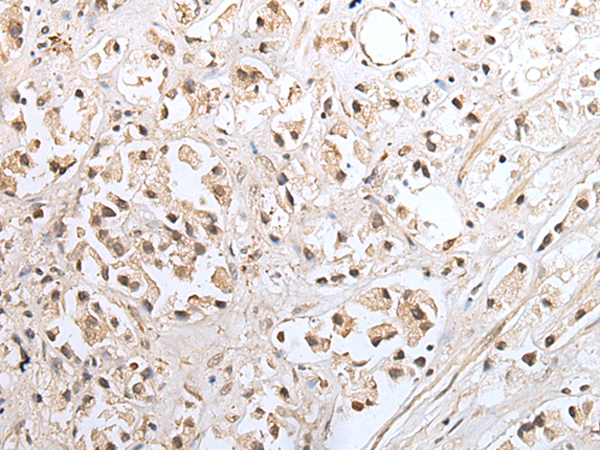

|
Background: |
SNF8, VPS25 (MIM 610907), and VPS36 (MIM 610903) form ESCRT-II (endosomal sorting complex required for transport II), a complex involved in endocytosis of ubiquitinated membrane proteins. SNF8, VPS25, and VPS36 are also associated in a multiprotein complex with RNA polymerase II elongation factor |
|
Applications: |
ELISA, IHC |
|
Name of antibody: |
SNF8 |
|
Immunogen: |
Full length fusion protein |
|
Full name: |
SNF8, ESCRT-II complex subunit |
|
Synonyms: |
Dot3; EAP30; VPS22 |
|
SwissProt: |
Q96H20 |
|
ELISA Recommended dilution: |
5000-10000 |
|
IHC positive control: |
Human gastric cancer and human prostate cancer |
|
IHC Recommend dilution: |
25-100 |
購物車
幫助
021-54845833/15800441009
